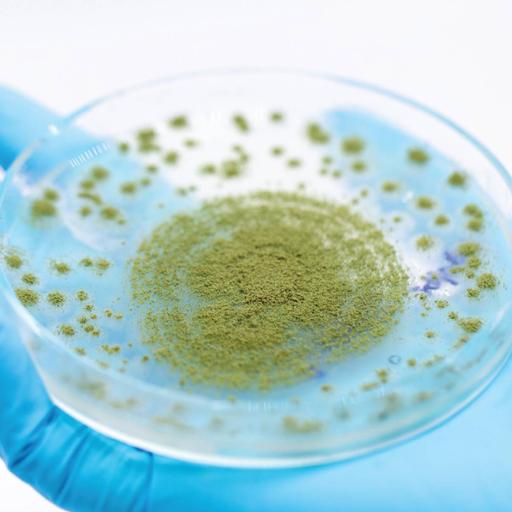

Gokul Pradeep
119 resources
A graduate in Computer Applications, Gokul has always enjoyed and spent most of his free time developing and writing content.
View more
A graduate in Computer Applications, Gokul has always enjoyed and spent most of his free time developing and writing content.
View more